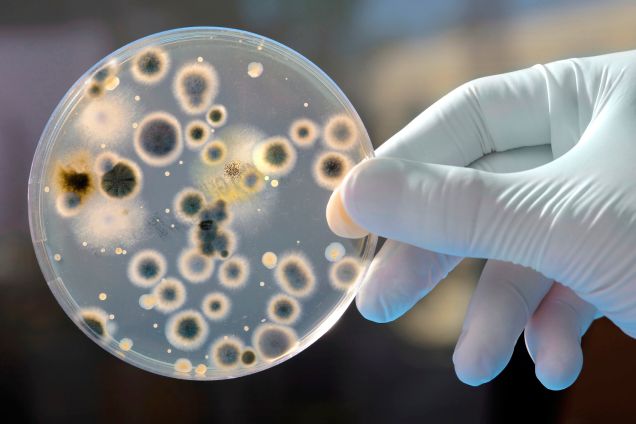

Lab Research
Laboratory hazards are as varied as the workers who face them. From light particle threats to toxic chemicals, every situation presents its own unique challenges. That’s why DuPont offers a range of protective fabric technologies that provide a level of comfort, durability and protection tailored to each worker’s specific needs. For cleanroom environments, DuPont offers its Tyvek® IsoClean® line of clean and sterile garments, which are specially designed and constructed for particle containment.
The products below are frequently selected for use in laboratories, but this is not a comprehensive list. Please click the Industry option in the Product Selector tool at the top of this page to specify your unique challenges and find the garment(s) that best suit your needs.
Day
Get answers to your questions within three working days, whereas queries requiring extensive research may take longer and will be answered as soon as possible.
.jpg)





.jpg)




